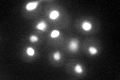
YGL070C
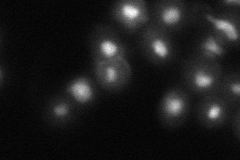
YGL070C
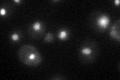
YGL070C

View description
RNA polymerase II subunit B12.6; contacts DNA; mutations affect transcription start site selection and fidelity of transcription
Localization:
Intensity:
Fold change:
Significance:
-
C’ GFP library in SD
nucleus61.66 -
N' NOP1pr-GFP in SD

nucleus122.829 -
N' TEF2pr-mCherry in SD

nucleus215.455 -
N' NATIVEpr-GFP in SD
nucleus44.371 -
N' TEF2pr-VC and Cyto-VN in SD

nucleus56.337 -
C’ GFP library in SD+DTT

nucleus63.981.03No -
C’ GFP library in SD+H2O2

nucleus61.510.99No -
C’ GFP library in Starvation Media
nucleus54.760.88No -
C’ GFP library on the background of Pup2-DaMP

nucleus -
C’ GFP library on the background of CCT mutant

nucleus14.10980.228789Yes
